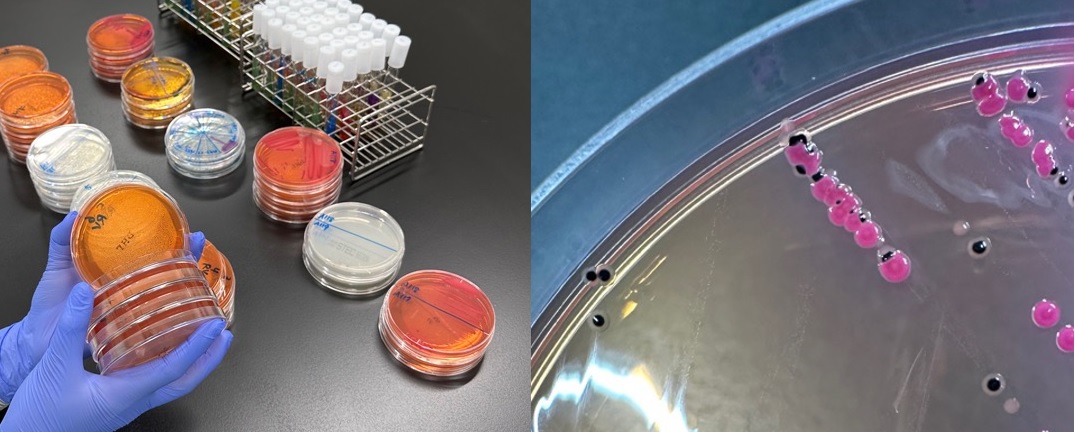
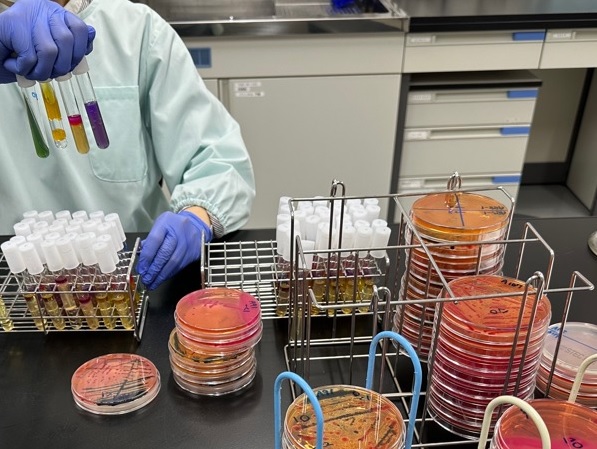

保健所検査課【検査課の業務紹介(微生物学的検査)】
登録日:2026年4月6日
ホーム検査受付保菌検査飲用水検査浴槽水検査食品検査業務紹介(理化学)よくある質問
検査課の業務紹介(微生物学的検査)
微生物学的検査部門と理化学的検査部門に分かれて検査を行っています。
微生物学的検査
微生物学的検査部門では、食品や飲用水、便の中に衛生上問題となる細菌やウイルスがいないか検査しています。
(1)保菌検査
便の中にサルモネラや赤痢菌、腸管出血性大腸菌などがいないか検査しています。
1日目:提出された便を培地に塗り、一定温度で1晩ほど培養します。

2日目:培地に生えた菌の確認をし、疑わしい菌は次の検査に進みます。
3日目以降:疑わしい菌が目的の菌かどうか判定をします。

(2)飲用水検査
- 持ち込まれたお水が飲めるかどうかの検査をしています。
- 微生物学的検査部門では、一般細菌数や大腸菌など細菌に関わる項目を担当しています。
1⃣検水を培地と混ぜて培養し、一般細菌数、大腸菌の検査をします。

2⃣大腸菌群がいると水の色が変化し、大腸菌がいると紫外線を当てると蛍光を発します。

(3)浴槽水検査(レジオネラ属菌)
レジオネラ症の原因となるレジオネラ属菌が浴槽水の中にいるのかを調べています。
1⃣浴槽水中の菌をフィルターに集めます。

2⃣フィルターに集めた菌を水に浮遊させ、培地に塗り広げ、一定温度で1週間ほど培養します。

3⃣培地に発育したレジオネラ様の菌を検査していきます。

(4)食品検査
食品の中に食中毒の原因になるような菌がいないか調べています。
1⃣食品をきざみ、袋に入れて計量後、希釈液を入れます。食品と希釈液をよく混ぜ、液状にします。

2⃣検出したい菌にあわせて色々な液体培地に液を入れたり、寒天培地に塗って、一定温度で1晩~2日ほど決められた時間培養します。

3⃣培地に変化があるか観察します。

(5)遺伝子検査(リアルタイムPCR)
目的の遺伝子(ノロウイルスの遺伝子や細菌の毒素遺伝子など)があるかどうか検査しています。
1⃣遺伝子検査用の試薬を混ぜ合わせ、プレートに入れます。試薬の入ったプレートに抽出した遺伝子を入れます。

2⃣プレートを装置にセットし、目的の遺伝子があるか調べます。

このページに関するお問い合わせ先
保健福祉部 保健所検査課
電話番号: 0246-27-8598 ファクス: 0246-27-8601